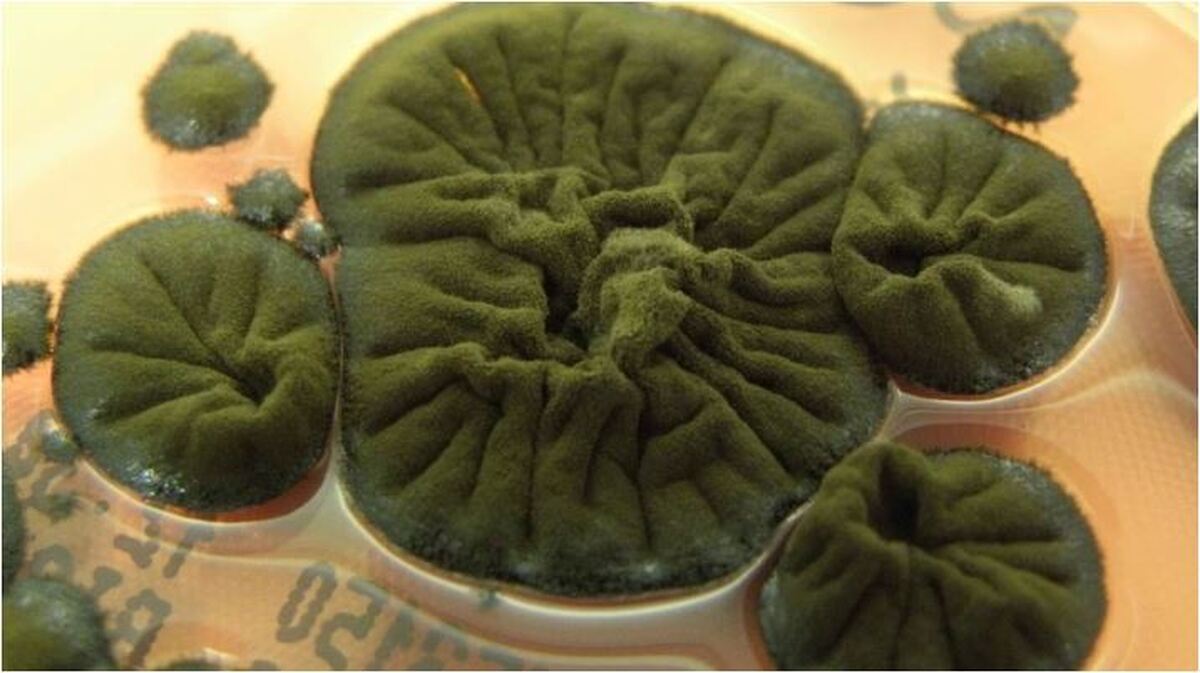
حتی تشعشعات هسته‌ای هم این قارچ را از بین نمی‌برد!

- ارتباط با ما
- |
- درباره ما
- |
- نظرسنجی
- |
- اشتراک خبری
- |
- نگارنامه
حتی تشعشعات هستهای هم این قارچ را از بین نمیبرد!
به گزارش مجله خبری نگار، وبگاه سایِنس اَلِرت در گزارشی آورده است:
نزدیک به چهار دهه پس از انفجار راکتور هستهای چرنوبیل در سال ۱۹۸۶ میلادی، که منطقه را به مکانی بهشدت آلوده و خطرناک تبدیل کرد، دانشمندان در کمال حیرت و شگفتی، در قلب ساختمانهای ویران نیروگاه، قارچ سیاه مرموزی به نام کلادوسپوریوم اسفروسپرموم (Cladosporium sphaerospermum) یافتهاند که نه تنها زنده مانده، بلکه در این محیط غیر عادی و آلوده به رشد خود ادامه میدهد.
جستوجوی حیات در سرزمین مرده
کشف این موجودات غیر منتظره به اواخر دهه ۱۹۹۰ میلادی بازمیگردد، هنگامی که گروهی به سرپرستی نلی ژدانووا (Nelli Zhdanova)، میکروبشناس اوکراینی، در پناهگاه راکتور ویرانشده به جستوجو پرداختند. آنها موفق به شناسایی ۳۷ گونه قارچ شدند که بسیاری از آنها تیرهرنگ و غنی از رنگدانه ملانین بودند.
ملانین: رنگدانهای با قدرت اسرارآمیز
نکته کلیدی در مقاومت حیرتانگیز این قارچ، به احتمال زیاد در همان رنگدانه تیره آن، یعنی ملانین، نهفته است. دانشمندانی مانند آرتورو کاسادوال (Arturo Casadevall) و اکاترینا داداچووا (Ekaterina Dadachova) نظریه جالبی را مطرح کردهاند: ملانین در این قارچها ممکن است با سازوکاری شبیه به فتوسنتز در گیاهان عمل کند، با این تفاوت که به جای نور مرئی، پرتوهای یونیزان را جذب و به انرژی شیمیایی تبدیل میکند. به این فرآیند فرضی رادیوسنتز (Radiosynthesis) میگویند. آزمایشها نشان دادهاند که قرار گرفتن در معرض تشعشعات نه تنها به این قارچ آسیب نمیزند، بلکه حتی رشد آن را تقویت میکند.
آزمایش نهایی در فضا: از چرنوبیل تا ایستگاه فضایی
دانشمندان برای آزمودن حد نهایی مقاومت این قارچ، در سال ۲۰۲۲ میلادی، نمونهای از آن را به ایستگاه فضایی بینالمللی بردند و آن را در خارج از ایستگاه، در معرض بمباران کامل تشعشعات کیهانی قرار دادند. نتایج شگفتآور بود: حسگرها نشان دادند میزان کمتری از تشعشع در مقایسه با نمونه شاهد (نمونه مقایسهای بدون قارچ، برای سنجش دقیق اثر)، از لایه قارچ عبور کرده است. هدف اصلی، بررسی امکان استفاده از قارچ بهعنوان سپر ضد تشعشع در مأموریتهای فضایی بود، اما این نتایج، پرسشهای بیشتری درباره سازوکار دقیق تعامل قارچ با تشعشعات ایجاد کرد.

معمای حلنشده: آیا رادیوسنتز واقعی است؟
با وجود همه شواهد جالب، اثبات قطعی فرضیه رادیوسنتز هنوز میسر نشده است. همانطور که گروه پژوهشی دانشگاه استنفورد به سرپرستی نیلس اورش (Nils Averesch) اشاره میکند، هیچکس تاکنون نتوانسته ثابت کند که این قارچ واقعاً از تشعشعات برای تثبیت کربن یا تولید انرژی متابولیک استفاده میکند. رفتار این قارچ منحصربهفرد است؛ زیرا سایر قارچهای حاوی ملانین، لزوماً چنین الگوی رشدی را نشان نمیدهند.
افق آینده: از اسطوره تا علم
پرسش بزرگی که باقی میماند این است: آیا این قارچ واقعاً تکامل یافته تا از مرگبارترین پرتوها تغذیه کند یا این واکنش، صرفاً یک سازوکار دفاعی برای بقا در شرایط سخت است؟ در حال حاضر، پاسخی قطعی در کار نیست؛ اما مسلم است که این موجود ساده بار دیگر ثابت میکند که حیات در غیرمنتظرهترین مکانها نیز راهی برای شکوفایی مییابد.
این کشف شگفتیهای طبیعت را به نمایش میگذارد و میتواند الهامبخش فناوریهای آینده در حوزه حفاظت در برابر تشعشع باشد. راز قارچ سیاه چرنوبیل، هنوز کامل کشف نشده، اما نشانههای قوی وجود دارد که مطالعه آن میتواند در آینده به دستاوردهای بزرگی مانند ساخت سپرهای ضدتشعشع برای فضانوردان یا حتی روشهای جدید تأمین انرژی منجر شود.
- لطفا از نوشتن با حروف لاتین (فینگلیش) خودداری نمایید.
- از ارسال دیدگاه های نا مرتبط با متن خبر، تکرار نظر دیگران، توهین به سایر کاربران و ارسال متن های طولانی خودداری نمایید.
- لطفا نظرات بدون بی احترامی، افترا و توهین به مسئولان، اقلیت ها، قومیت ها و ... باشد و به طور کلی مغایرتی با اصول اخلاقی و قوانین کشور نداشته باشد.
- در غیر این صورت، «نگارمگ » مطلب مورد نظر را رد یا بنا به تشخیص خود با ممیزی منتشر خواهد کرد.




- آخرین اخبار
- محبوب
- برچسب های داغ
- عوارض پوشیدن لباس زیر تنگ و جوراب شلواری
- فیلم| سقوط جنگنده اف-۱۶ آمریکایی در جنوب کالیفرنیا در حین ماموریت آموزشی
- مطالعه: شمارش با انگشتان، راه را برای پیشرفت در ریاضیات هموار میکند
- «تخممرغ زمستانی» اثر فابرژه از مجموعه نیکولای دوم به قیمت ۲۵.۷ میلیون دلار فروخته شد
- یک شوک سلامتی: «چربی شکم» برای سلامتی شما از وزن کل بدن خطرناکتر است!
- سازمان ملل: هر ۱۰ دقیقه یک زن توسط یکی از بستگان نزدیک خود کشته میشود
- همتیمی سابق نیمار درباره ترس از فضاهای بسته و یک اتفاق خندهدار در توالت صحبت کرد
- نظرسنجی: بیش از نیمی از آلمانیها زندگی را استرسزاتر از گذشته میدانند
- عکس + ویدیو| «خانه قلب است»: ملانیا ترامپ از تزئینات کریسمس کاخ سفید رونمایی کرد
- «راه حل معدنی معجزه آسا»: درمانی معجزه آسا یا توهمی سمی که بدن ما را نابود میکند؟
- لامین یامال معنی حرکت «۳۰۴» را در شادیهای پس از گل توضیح داد
- لامین یامال: مسی بهترین تاریخ است، اما من میخواهم راه خودم را بروم
- آیا شمردن گوسفندان به خواب رفتن سریع کمک میکند؟
- ویدئو| یک خرس سیاه در بازار کریسمس در تنسی آمریکا پرسه میزند!
- یک دانشمند روسی با دلیل پیش بینی کرد که طول عمر انسان به ۱۲۰ سال افزایش خواهد یافت
- بین انرژی و فیبر: چگونه موز را بر اساس نیازهای تغذیهای خود انتخاب کنیم؟
- هر آنچه که باید در مورد قرعه کشی مرحله گروهی جام جهانی ۲۰۲۶ بدانید
- فیلم| آب آشامیدنی کریستیانو رونالدو در مساجد جده توزیع میشود
- کشف ۸ الگوی «کووید طولانی» راه را برای درمانهای جدید هموار میکند
- غذاهایی که به تولید "هورمون شادی" کمک میکنند
- لخته شدن خون عامل مرگ در بیماری سرطان!
- اهرام باستانی مصر عجیبتر از آنچه تصور کنید!
- کیفیت آب شرب در ایران چگونه است؟
- کودکانی که تا سن ۱۲ سالگی گوشی دارند، بیشتر افسرده میشوند!
- رژیم غذایی پرچرب چگونه روده را تحت تاثیر میدهد؟
- شش خوراکی مناسب برای سالمندان!
- کشف ۵۳ اختروش جدید که از سیاه چالهها رشد میگیرند!
- ظرفیت نصبشده انرژیهای تجدیدپذیر در ایران افزایش یافته است!
- همهگیری آنفلوآنزا تا چه زمانی ادامه دارد؟
- تقویت سیستم ایمنی کودکان در برابر آلودگی هوا با رعایت این نکات!
- ایده اینترنت فضایی چقدر به عملی شدن نزدیک است؟
- تاثیر آلودگی هوا بر سرطانهای دستگاه گوارش!
- اشتباهات رایج در یوگا را بشناسید!
- با تفاوت انواع دیابت آشنا شوید!
- هوش مصنوعی عامل ناعدالتی بین کشورها!
- در شناسایی موجودات فرازمینی به کجا رسیدهایم؟
- مقصر آلودگی هوا در کلانشهرها چیست؟
- آبشار زمانسنجهای مولکولی در ذخیرهسازی اطلاعات در حافظه نقش دارند!
- وسواس چک کردن میتواند خطرناک باشد؟
- توصیههای طب ایرانی در هوای آلوده چیست؟
- حتی یک استرس کوچک هم سالها بعد به عامل ریزش مو تبدیل میشود!
- آزمایشهای منظم خون برای پیگیری روند آلزایمر اهمیت دارد!
- تغییرات طراحی مدل اقتصادی آیفون چگونه است؟
- استفاده از لرزش اولتراسونیک بحران جهانی آب را از بین خواهد برد!
- امکان تصویربرداری مادونقرمز با الهام گرفتن از مارها!
- آشنایی با سریعترین راه درمان آنفولانزا در خانه!
- حذف صبحانه باعث چاقی و مشکلات قلبی میشود!
- بیشترین خطر آنفلوآنزا برای کدام گروه سنی است؟
- مصرف زیاد انار و خرمالو باعث درد شکمی در کودکان میشود!
- بررسی تاثیرات گسترده آلودگی هوا بر سلامت عمومی!
- مهمترین اقدام مقابلهای با آنفلوآنزا، اهمیت رعایت بهداشت است!
- چه نکاتی را باید در آلودگی هوا رعایت کرد؟
- در هوای آلوده، فعالیت ورزشی در فضای باز ممنوع!
- کوتاهی عضلات پشت ران عاملی برای کمردرد!
- درمان بهموقع ایدز را کنترل میکند!
- مهمترین ویروس در گردش این فصل چیست؟
- چیزی که خواب میبینیم با سن ما ارتباط دارد؟
- سرماخوردگی معمولی خطر ابتلا به کرونا را کاهش میدهد!
- عرق بدن مناسب برای نظارت بیماریها!
- اگر قصد رنگ مو دارید، بخوانید!
- نشانه ضرورت مراجعه به روانپزشک را بشناسید!
- در هوای آلوده چگونه از پوست خود مراقبت کنیم؟
- افزایش مصرف برخی داروها در آستانه فصل زمستان!
- روند پیشگیری و درمان HIV چگونه پیش میرود؟
- چه چیزی سرطان را کشنده میکند؟
- ویروس آنفلوانزا بیشتر تهدیدی برای کودکان ۵ تا ۱۴ ساله است!
- بیحسی و گزگز ساق پا نشانه چه بیماری است؟
- برای درمان آنفلوآنزا آنتیبیوتیک مصرف نکنید!
- تهویه مناسب گردش ویروسها را محدود میکند!
- از فواید شناختهشده ورزش منظم جا نمانید!
- مصرف داروهای کاهش وزن عوارض دارند؟
- تولید گرافن از پسماندهای کربنی ممکن شد!
- روزهای آزاد در رژیم غذایی، کاهش وزن بهتری رقم میزند!
- بیماران دیابتی باید چه نکات تغذیهای را رعایت کنند؟
- سلولها چطور وظایف خود را به درستی انجام میدهند؟
- برای پیشگیری از سنگ کلیه به رعایت این نکات نیاز دارید!
- استفاده از هوش مصنوعی یادگیری را کاهش میدهد یا افزایش؟
- کشف اطلاعاتی عجیب از حبابهای گاز آتشفشانی!
- کشف رفتار زیرگونهای از سلولهای ایمنی مغز در برابر آلزایمر!
- بیشترین شانس موفقیت برای فرزند آخر!
- عکس| فلاویو بریاتوره در گرند پری فرمول یک با دیوید بکهام ملاقات کرد
- شانزده سال پس از مرگ او، گزارشی حقایق تکان دهندهای را در مورد کالبدشکافی این ستاره جهانی موسیقی پاپ فاش میکند
- خانواده بروس ویلیس با وخامت حال او، «تصمیمی دشوار» میگیرند
- کاردی بی از بند ناف فرزندش یک گردنبند طلا درست کرد
- مدونا مخفیانه با معشوق ۲۹ سالهاش نامزد کرده است
- کیت میدلتون و پرنس ویلیام به خاطر نحوه تشکر از کارکنانشان مورد انتقاد قرار گرفتهاند
- اشنایدر در یک نظرسنجی سریع به سوالات پاسخ داد: «کریستیانو رونالدو یا رافائل نادال؟»
- همسر سابق جنیفر آنیستون به رابطه نامشروع همسرش با یک متخصص هیپنوتیزم درمانی واکنش نشان داد
- کیران کالکین برای سومین بار پدر شد
- جزئیات رابطه عاشقانه سوفی ترنر با همسر سابق گوئینت پالترو فاش شد
- ریس ویترسپون در مورد رابطه جنیفر آنیستون با پیت: «او کسی نیست که به گذشته بچسبد.»
- رسوایی تکاندهنده درباره یک میلیاردر جهانی: او عاشق جفری اپستین، مجرم جنسی، بود، اما!
- جنیفر لارنس توضیح داد که چرا دیگر از ترامپ انتقاد نمیکند: «این کار به آتش ماجرا دامن میزند.»
- نحوه برخورد با شاهزاده هری و مگان مارکل در هالیوود فاش شد
- کیم کارداشیان گفت که به دلیل هوش مصنوعی در امتحانات حقوق خود رد شده است
- مشخص شد که چرا شاهزاده هری از مگان مارکل ناراضی است
- ریچارد گیر راز یک ازدواج شاد را فاش میکند: «من یاد گرفتم که پدر خوبی باشم»
- ستاره فیلم «ایفوریا» برای اولین بار درباره رسوایی تبلیغات شلوار جین صحبت میکند: «یک واکنش غیرمنتظره»
- آلکاراز: من بیشتر اسپانیایی هستم تا یک هوادار رئال مادرید
- کیتی پری دلیل جداییاش از اورلاندو بلوم را فاش کرد
- تیموتی شالامی برای اولین بار درباره رابطهاش با جنر صحبت میکند: «دوست دارم پدر بودن را تجربه کنم.»
- شوهر سابق جنیفر لوپز این بازیگر را به خیانت متهم کرد: «مشکل از خود توست.»
- دلیل واقعی نقل مکان کیت میدلتون به خانه جدید فاش شد
- جنیفر آنیستون درباره رابطهاش با یک متخصص هیپنوتیزم صحبت میکند: «غیرعادی»
- راز انتخاب گوشوارههای کیت میدلتون در محل کار فاش شد
- شوارتزنگر طرح خود را برای «حفظ دموکراسی» در ایالات متحده مطرح کرد
- سلنا گومز در پاسخ به انتقاد هیلی بیبر گفت: «او میتواند هر چه دلش میخواهد بگوید.»
- نظر جاستین بیبر در مورد اختلاف همسرش با سلنا گومز فاش شد
- مشخص شد که چرا پسر بکهامها سعی نمیکند با والدینش آشتی کند
- نیکول کیدمن پس از انتشار خبر طلاقش، میخواهد دوباره با کیث اربن رابطه برقرار کند
- ویکتوریا بکهام درباره قلدری در مدرسه صحبت کرد: «آنها به من میگفتند احمق.»
- دمی مور درباره شغل غیرمعمولی که در ۱۴ سالگی داشت صحبت کرد
- ستاره هالیوود پس از نبردی دردناک با زوال عقل، در بستر مرگ است
- «از صمیم قلب دلم برایت تنگ شده.» لیونل مسی از ورزشگاه بازسازی شده بارسلونا بازدید کرد
- همسر جاستین بیبر در بحبوحه رسوایی گومز، از برنامه خود برای فرزند دوم خبر داد
- کیرا نایتلی توضیح داد که چرا دخترانش را از استفاده از رسانههای اجتماعی منع کرده است
- کیم کارداشیان تغییر مسیر شغلی خود را اعلام کرد
- رامی ملک، بازیگر بینالمللی متولد مصر: برای گرفتن نقشم در این فیلم جنگیدم!
- تینا کندلاکی، ۴۹ ساله، راز ظاهر آراستهاش را فاش کرد
- رونالدو گفت که حتی ترامپ هم از او محبوبیت کمتری دارد
- مشین گان کلی معتقد است که او و مگان فاکس به دلیل چشم زخم از هم جدا شدند
- نامزد سابق تیماتی عوارض تزریقات زیبایی روی بازوهایش را نشان داد: "من هرگز به آن عادت نخواهم کرد. "
- یک دلیل غیرمنتظره آنجلینا جولی را مجبور میکند وارد یک دفتر استخدام نظامی در اوکراین شود
- کندال جنر اعتراف کرد که در کودکی به خواهرش حسادت میکرده است: «حسادت میکردم.»
- شوهر خواننده سیا او را به اعتیاد به مواد مخدر متهم کرد
- همسر ۶۱ ساله باراک اوباما راز زیبایی خود را فاش کرد: «من اخم نمیکنم».
- کیم کارداشیان رابطه اش با دختر ترامپ را فاش کرد
- دلیل نفرت شاهزاده ویلیام از شاهزاده اندرو فاش شد
- کیت میدلتون و ملکه کامیلا اصرار داشتند که شاهزاده اندرو از عناوین خود محروم شود
- دلیل اینکه کیت میدلتون و پرنس ویلیام نقل مکان به خانه جدید را تسریع کردند، فاش شد
- جنیفر آنیستون در کنار نامزد هیپنوتیزم درمانگرش در سریال «عشق من» بازی میکند
- مدونا مخفیانه با معشوق ۲۹ سالهاش نامزد کرده است
- ستاره جنجالی فیلم «ایفوریا» با نامزد سابقش در ماشین مشاجره کرد
- کیت میدلتون و پرنس ویلیام به خاطر نحوه تشکر از کارکنانشان مورد انتقاد قرار گرفتهاند
- ناسا به تردیدهای کیم کارداشیان در مورد فرود بر ماه پاسخ داد
- عکس| مل گیبسون جنجالی بر سر مریم مقدس به پا کرد
- ابتلا به «ویروس اهداکننده»| یک بازیگر مشهور آمریکایی قصد دارد کلیه خود را به یک غریبه اهدا کند
- همسر سابق آرشاوین: او بنتلی من را فروخت، یک مرسدس خرید و مابهالتفاوت را برای خودش نگه داشت
- مسی بهترین ورزشکاران در بین تمام رشتههای ورزشی را انتخاب کرد
- دلیل پاملا اندرسون، ۵۶ ساله، برای کنار گذاشتن آرایش
- حمایت بانکها از بازار سرمایه از فردا اجرا میشود
- بورس سقوط کرده در دولت روحانی چگونه در دولت شهید رئیسی احیا شد؟
- درمان بورسی پزشکیان از زبان عبده
- جذب سرمایه ۷ همتی از بازار بورس دانشبنیانها
- وعده عناب بورسی واقعیتر شد
- چهارمین روز نزولی بازار در غیاب نیروهای صعودی
- انتخابات و دامنه نوسان مهمترین دلیل رکود فعلی بورس
- بورس با ۴ مصوبه دولت برای حمایت از بازار سهام سبزپوش میشود؟
- ۳ دلیل پایین بودن ارزش معاملات خرد در بورس
- معافیتهای مالیاتی بازار سرمایه باید استمرار پیدا کند
- بورس این روزها تحت تأثیر تداوم نرخ اخزای بالای ۳۵ درصد
- رشد شاخصهای بورس با کف سازی تکنیکال
- کاهش دامنه نوسان هم علاج بورس نزولی نبود
- سایه تامین مالی دولت بر سر بورس سنگینی میکند
- کاهش بی سابقه حجم معاملات سهام در بورسهای جهانی
- رشد شاخصهای بورس با کمک بانکیها و اعلام نرخ تسعیر ارز
- حمله به سفیر روسیه در لهستان
- معرفی سری گوشیهای Redmi K ۵۰ قبل از رونمایی رسمی
- غفوری: فکر کردن به قهرمانی از الان، سادهلوحانه است
- کاهش ۱۰ درصدی تولید هوندا در دو کارخانه
- سومین نشست دستمزد، باز هم بدون نتیجه
- لغو بلیت فروشی عمومی المپیک زمستانی چین
- گرامیداشت قربانیان هواپیمای اوکراینی در دانشگاه تورنتو
- ادامه چانهزنی چهارگانه در وین
- صرفهجویی ۱.۶ میلیارد دلاری کمیته برگزاری المپیک و پارالمپیک توکیو
- محبوبترین رشته المپیک توکیو مشخص شد
- اعلام هزینه میزبانی توکیو از المپیک و پارالمپیک ۲۰۲۰،
- آذرتاج: هیات اقتصادی جمهوری آذربایجان به ایران میرود
- بررسی عملکرد ایران در المپیک؛ جایگاه چهارمی در آسیا
- پایان وضعیت اضطراری در کشور میزبان المپیک ۲۰۲۰
- سه عادت صبحگاهی که به لوزالمعده فشار میآورد و خطر ابتلا به دیابت را افزایش میدهد
- از عطر خون تا «شراب نیکا»| دکان بازیهای وطن فروشان
- مناظره خوب مثل کاشانی
- روان اجتماعی هدف سنگهای رسانه
- این روز سیاه را از ما دور کنید!؟
- ماجرای بلای روزهای بدون نور
- همیشه آنلاینهای مضطرب| هجوم فضای مجازی روی روان کودکان و نوجوانان
- ۵ فایده علمی اثبات شده که زنجبیل را در رژیم غذایی شما ضروری میکند
- علت پنهان شوره سر آزاردهنده
- متخصصان روابط توضیح میدهند که چرا مردان علاقه خود را به رابطه جنسی از دست میدهند.
- هزاران گالن شیر به دلیل احتمال آلودگی به مواد شوینده از بازارهای آمریکا جمعآوری شد
- از دست دادن صدا میتواند با بیماری تیروئید و تعدادی از بیماریهای دیگر همراه باشد.
- دو عامل کلیدی برای موفقیت طولانی مدت در کاهش وزن یک فرد هستند
- کارشناسان در مورد خطرات این سه محصول پرطرفدار برای مغز انسان هشدار دادهاند.
- دانشمندان دریافتهاند که سبک زندگی بیتحرک منجر به بزرگ شدن قلب در نوجوانان میشود.
- رانندگی با ماشین جدید میتواند برای سلامتی شما پرهزینه باشد.
- تزریق پپتیدی که آنزیم را هدف قرار میدهد ممکن است بیماری آلزایمر را معکوس کند
- سمعک ممکن است خطر زوال عقل را در افراد مبتلا به کم شنوایی کاهش دهد
- فواید سلامتی خوردن گردو آشکار شد
- آزمایش مولکول قند خون میتواند به تشخیص زودهنگام بیماری آلزایمر کمک کند
- ویپهای بدون نیکوتین به اندازه ویپهای حاوی نیکوتین اعتیادآور هستند
- سیب ممکن است از چاقی و بیماری آلزایمر جلوگیری کند
- دانشمندان مکملی را کشف کردهاند که میتواند از زوال عقل محافظت کند و مغز را "جوانسازی" کند.
- خطرناکترین محصول یخچال شناسایی شد
- متخصصان زنان و زایمان روشهای مؤثری برای درمان درد هنگام رابطه جنسی در دوران یائسگی شناسایی کردهاند.
- خونریزی لثه میتواند باعث بدتر شدن آرتروز شود.
- گرینپیس: لباسهای فروخته شده از طریق شین حاوی مواد شیمیایی خطرناک هستند
- کمبود خواب مزمن با آلودگی هوا مرتبط است
- دولت آمریکا به دنبال حکم دادگاه برای متوقف کردن عملیات تبلیغات آنلاین گوگل است
- هفت فایده فلفل سیاه برای سلامتی که از نظر علمی تایید شدهاند، آشکار شد.
- دانشمندان دانشگاه هاروارد، قهوه را به عنوان جایگزینی برای نوشابه برای کاهش خطر ابتلا به دیابت معرفی کردند.
- دانشمندان دریافتهاند که فلاونوئیدها خطر ابتلا به ضعف در سالمندان را کاهش میدهند.
- دانشمندان کشف کردهاند که چگونه میتوان تنها با ۳۰ دقیقه در روز، ۱۶ سال به عمر اضافه کرد.
- یک هنرمند مصری اعلام کرد که به جهش استراتوس مبتلا شده است و در مورد علائم آن هشدار داد
- پزشکان توضیح دادند که چگونه سرطان در بدن انسان ایجاد و گسترش مییابد.
- یک متخصص قلب و عروق سه روش ساده برای کاهش خطر ابتلا به بیماریهای قلبی توصیه میکند.
- وزیر دارایی آلمان مزایایی را برای استفاده از تلفنهای هوشمند در مدارس میبیند
- دانشمندان کشف کردهاند که سوزاک میتواند از طریق بوسیدن منتقل شود.
- هوس سیبزمینی سرخکرده با افزایش خطر اضطراب و افسردگی مرتبط است
- بیش از ۶۰۰ نوزاد در سال ۲۰۲۴ در فرانسه قربانی خشونت جنسی شدند
- ارز
- طلا
- بورس
- تورم
- اخبار داغ
- ورزشی
- پربیننده
- پربحث
- کاهش سطح کلسترول "بد" خطری برای سلامتی محسوب میشود.
- ترامپ: شرایط برای حل و فصل بحران اوکراین پس از دیدار من با زلنسکی برای کییف بدتر شده است
- سفیر روسیه: کانالهای ارتباطی بین ناتو و سفارت روسیه در بلژیک همچنان برقرار است
- تحریمها علیه روسیه به ۳۱۰۰۰ مورد نزدیک میشود و ایالات متحده در صدر این فهرست قرار دارد
- مدودچوک نابودی اوکراین را پیشبینی کرد
- در مالزی، ساسها برای کار به عنوان بازرسان پزشکی قانونی آموزش دیدهاند.
- رئیس جمهور ونزوئلا: گفتگوی دوستانهای با ترامپ بر اساس احترام متقابل داشتم
- وزیر امور خارجه: ونزوئلا پروازهایی حامل شهروندان اخراجی از ایالات متحده و مکزیک دریافت کرد
- تاریخ بازگشت میخائیل مدریک و باشگاه جدید احتمالی او در انگلیس اعلام شد
- رئیس سابق دیپلماسی اروپا مظنون به اختلاس بودجه است.
- یک روش ساده برای افزایش مقاومت قلب در برابر استرس شناسایی شده است.
- وزارت امور خارجه روسیه، غرب را به حمایت از تروریسم در اوکراین متهم کرد.
- یک روش ساده برای تسکین علائم افسردگی در ۳۰ دقیقه شناسایی شده است.
- چاپگری برای ترمیم زخمهای پیچیده در حین عمل جراحی در روسیه رونمایی شد.
- غرب تشدید درگیری بین کالاس و فون در لاین را پیشبینی کرد.
- گروهی از غذاها که خطر ابتلا به سرطان ریه را افزایش میدهند، شناسایی شدهاند.
- پسکوف عواقب خودداری از خرید گاز روسیه برای اروپا را فاش کرد.
- دانشمندان از واکنش پنهان بدن به موسیقی شگفت زده شدند.
- پسکوف واکنش پوتین به طرح صلح ترامپ برای اوکراین را ارزیابی کرد.
- یک مغز که میتواند از سلامت قلب پشتیبانی کند، معرفی شد.
- کرملین در مورد نشست روسای جمهور و وزارت امور خارجه در مورد اوکراین اظهار نظر کرد.
- دانشمندان کشف کردهاند که ترنج میتواند از بیماری کبد چرب جلوگیری کند.
- رویدادی شناسایی شده است که میتواند خطر ابتلا به زوال عقل را تا ۸۳ درصد افزایش دهد.
- روسیه از سیستم تشخیص زودهنگام سرطان سه مرحلهای رونمایی کرد
- فون در لاین از «طلوع دورانی جدید» برای اتحادیه اروپا سخن گفت
- مشخص شده است که چگونه سازگاری جنسی بر آینده یک رابطه تأثیر میگذارد.
- یک کارشناس نظامی توضیح داد که چه کسی پشت حملات کیف به نفتکشها در دریای سیاه است.
- یک رژیم غذایی دقیق برای کند کردن روند پیری مغز شناسایی شده است.
- سیاستمدار اوکراینی: بریتانیا به اوکراین دستور حمله به نفتکشهای روسی را داده بود
- دانشمندان اثر غیرمنتظرهای از قهوه بر اسکیزوفرنی کشف کردهاند.
- زلنسکی پس از دیدار پوتین و ویتکوف، گامهای بعدی را تشریح کرد.
- مشخص شده است که یک جایگزین قند «ایمن» دارای یک ایراد قابل توجه است.
- نخست وزیر سابق اوکراین پیشرفت مذاکرات برای حل و فصل بحران اوکراین را ارزیابی کرد.
- دانشمندان روسی یک قانون جهانی حاکم بر رفتار رباتها را کشف کردهاند.
- ناتو از روبیو میخواهد مذاکرات با روسیه را در اولویت قرار دهد.
- دانشمندان دریافتهاند که یک نوشیدنی رایج، تراکم استخوان را در زنان افزایش میدهد.
- دبیرکل ناتو: طرح صلح آمریکا در اوکراین موفقیتآمیز خواهد بود
- پنتاگون: گزارشهای جعلی رسانهها درباره حملات آمریکا به قاچاقچیان مواد مخدر، ترامپ و هگزث را هدف قرار میدهد
- کوستین اظهار داشت که روسیه خواهان صلح با ایالات متحده است.
- یک پزشک توضیح داد که چگونه از شروع زوال عقل جلوگیری کنیم.
- یک کارشناس نظامی به تغییر در روحیه مردم اوکراین اشاره میکند
- گزارشی از نزدیکترین تیم عربستانی به جذب محمد صلاح خبر میدهد
- نروژ یکی از پایگاههای هوایی ناتو را تعطیل کرد.
- دانشمندان روسی کارایی اکتشاف نفت را بهبود بخشیدهاند.
- کرملین به سوالی در مورد رسوایی فساد در اروپا پاسخ داد.
- دانشمندان افسانههای رایج در مورد عوامل ضد یخ را رد کردهاند.
- وزارت امور خارجه بلژیک جایگزینی برای تأمین مالی کیف بدون توقیف داراییهای روسیه پیدا کرده است.
- دانشمندان از تأثیر خطرناک آفتکشها بر عملکرد روده نگران هستند.
- بریتانیا قول داده است که به «روشن کردن دوباره چراغها» در اوکراین کمک کند.
- یک پیشرفت بزرگ در اخترفیزیک قرن بیست و یکم حاصل شده است.
- وزارت امور خارجه الجزایر: مداخلات خارجی باعث میشود آفریقا ابتکار عمل خود را از دست بدهد و اکنون راه حل در دست "بیگانگان" است
- روته مذاکرات صلح را از بحثهای مربوط به پیوستن اوکراین به ناتو جدا کرد
- ترکیه حملات به کشتیها در دریای سیاه را غیرقابل قبول خواند
- کشف ستارگان تاریک مرموز در کیهان
- یک مقام ارشد روسی: سیستم مالی سنتی غربی به تدریج در حال محو شدن است
- روبیو اظهار داشت که صلح در اوکراین تنها با میانجیگری آمریکا میتواند حاصل شود.
- دنیای کوانتومی حتی عجیبتر از آن چیزی بود که قبلاً تصور میشد.
- یک ماهواره «مصرفشده» در سال ۲۰۲۹ به ابزاری علمی برای رصد سیارک آپوفیس تبدیل خواهد شد!
- چهار کشور اروپایی مخالفت خود را با برنامههای اوکراین در مورد پیمان اتاوا ابراز کردند
- رئیس جمهور فنلاند آخرین فرصت غرب را اعلام کرد
- دانشمندان درباره خطرات مرگبار خالکوبی هشدار میدهند
- ترامپ: ایالات متحده به زودی هدف قرار دادن قاچاقچیان مواد مخدر در خشکی را آغاز خواهد کرد
- مراکش: پلیس پس از از دست دادن پول در معاملات تجاری آنلاین به زندگی خود پایان داد
- زلنسکی درباره احتمال پایان دادن به درگیریها در اوکراین صحبت کرد.
- داروی آکنه در پیشگیری از اسکیزوفرنی موثر است
- نخست وزیر ژاپن به دلیل اظهاراتش در مورد جزایر کوریل با انتقاد روبروست
- شبکه خبری سیبیاس به نقل از مقامات آمریکایی گزارش داد: دولت ترامپ در حال بررسی گسترش ممنوعیت سفر به آمریکا است
- ترامپ، بایدن را به کاهش ذخایر نفتی متهم کرد
- محصولاتی که مغز را از بیماری آلزایمر محافظت میکنند، شناسایی شدهاند.
- ترامپ درباره رابطهاش با ماسک صحبت کرد
- راهی برای جلوگیری از آسیب عصبی ناشی از دیابت پیدا شده است.
- ناتو به بیانیه پوتین در مورد آمادگی این سازمان برای جنگ با اروپا واکنش نشان داد.
- دانشمندان کشف کردهاند که راکونها شروع به اهلی کردن خود کردهاند.
- روسیه و ایالات متحده به همکاری خود برای دستیابی به توافق در اوکراین ادامه خواهند داد.
- مراحل کلیدی تغییرات مغز در طول زندگی شناسایی شدهاند.
- پوتین: مقامات کییف در سیاره دیگری زندگی میکنند و مشغول گدایی پول هستند
- اوشاکوف درباره توافق روسیه و ایالات متحده مبنی بر عدم افشای ماهیت مذاکرات صحبت کرد.
- محصولی که اشباع اکسیژن عروقی را افزایش میدهد، نامگذاری شده است.
- فرانسه: ۱۷۰۰۰ معترض در پاریس علیه پیشنهاد بودجه ۲۰۲۶
- روبیو از مذاکرات اوکراین کنار گذاشته شد
- جزئیاتی در مورد مصدومیت دو بازیکن رئال مادرید در بازی لالیگا منتشر شد
- یک هدف بلندمدت برای باشگاه فوتبال بارسلونا
- نیمار در مورد آینده اش صحبت کرده است. قرارداد او با سانتوس در پایان ماه دسامبر به پایان میرسد
- DFB Pokal | بایرن مونیخ کار خود را در برلین انجام میدهد
- فلامینگو پیش از موعد مقرر، با شکست دادن سئارا به لطف پاس کاراسکال، عنوان قهرمانی برزیل را از آن خود کرد
- کوپا ایتالیا | اینتر میلان حریف خود را در هم کوبید و اکنون به مرحله یک چهارم نهایی راه یافت
- یکی از استعدادهای برتر لیگ برتر میتواند به منچستر یونایتد بپیوندد| آموریم به این بازیکن علاقهمند است
- الخاندرو گریمالدو، در کانون توجه
- فابریزیو رومانو اطلاعات محرمانهای در مورد آینده تراشتگن، دروازهبان بارسلونا، به اشتراک گذاشت
- حرکات تیمو ورنر
- شان دایچ، سرمربی ناتینگهام، در مورد وضعیت سلامتی اولکساندر زینچنکو بیانیهای صادر کرد
- لیگ برتر | فلوریان ویرتز لیورپول را نجات داد
- «لالیگا فاسد است.» تلویزیون باشگاه رئال مادرید از عملکرد داوران در مسابقات این تیم انتقاد کرد
- پپ گواردیولا، مستقیماً در مورد فیل فودن صحبت کرد
- «آلونسو مشکل نیست.» اتلتیک دلیل تنش در رئال مادرید را عنوان کرد
- فران تورس، مورد نظر
- وینیسیوس جونیور، داستان بی پایان
- رئال مادرید پنج بازیکن مازاد خود را معرفی کرد
- جواهری که آرسنال زیر نظر دارد
- مایک میگنان در کانون توجه
- مدیر ورزشی بایرن مونیخ درباره نویر: من او را یکی از بهترین دروازهبانان جهان میدانم
- اسلات - درباره صلاح: البته، اگر یک بازیکن بازی نکند، ناراضی است
- آرسنال در حال برنامهریزی برای یک خرید ۱۲۰ میلیون یورویی است!
- ژابی آلونسو ریسک بزرگی کرده است... و از همین حالا صحبت از دو جایگزین احتمالی است
- تصمیمی مهم از مایلز لوئیس-اسکلی
- کاپلو در مورد نقل و انتقالات: مهاجمان میانی؟ آنها کجا هستند؟
- آرتتا درباره دکلان رایس: او در لحظات کلیدی بهتر میشود
- اولی هوینس در مورد تمدید قرارداد احتمالی با اوپامکانو صحبت کرده است
- تصمیم گرفته شد: رئال مادرید دو اولویت برای بازار نقل و انتقالات دارد
- اتلتیکو مادرید و منچسترسیتی به فکر جذب مارک کوکورلا بودند
- تونی کروس پیام روشنی به رئال مادرید فرستاد
- لیورپول و آرسنال میتوانند رودریگو را در زمستان با ۸۵ تا ۹۰ میلیون یورو از رئال مادرید به خدمت بگیرند
- روزنامه اتلتیک جزئیاتی درباره آینده لواندوفسکی و رشفورد در بارسلونا به اشتراک گذاشت
- باشگاه رئال مادرید در مورد مصدومیت جدید فرلاند مندی بیانیهای صادر کرد
- میکل مرینو باعث ایجاد هیجان میشود
- سعید ال مالا تنها گزینه نیست: گزینه جایگزین برای بایرن مونیخ
- دو بازیکن نیس پس از حمله هواداران مجروح شدند
- گواردیولا درباره فودن: امیدوارم او تا آخر دوران حرفهایاش در این باشگاه بماند
- فردیناند در مورد بوکایو ساکا: او به اندازه محمد صلاح قوی است
- انزو فرناندز در مورد تیم ملی آرژانتین: ما تمام تلاش خود را برای حفظ عنوان قهرمانی انجام خواهیم داد
- دوئل سه جانبه فوق العاده برای جذب تینو لیورامنتو
- مانوئل نویر، مرموز
- رائول میخواهد به رئال مادرید برگردد
- رئال مادرید علاقهمند به جذب مدافع اینتراخت فرانکفورت است
- نیکو شلاتربک قرارداد خود را با بوروسیا دورتموند تمدید نخواهد کرد
- زلاتان ابراهیموویچ به عنوان مشعلدار المپیک زمستانی ۲۰۲۶ انتخاب شد
- جدال بارسلونا و رئال مادرید بر سر جذب یک مدافع میانی
- سویا اجازه داد بهترین گلزن لیگ اروپا از دست برود
- یک تصمیم رادیکال در مورد رودریگو!
- ساها در مورد نیمار: او ممکن است شور و شوق خود را از دست داده باشد. این غم انگیز است
- ESPN فاش کرد که وینیسیوس و رئال مادرید چه زمانی میتوانند مذاکرات خود را برای تمدید قرارداد از سر بگیرند
- کوین لنینی: راهیابی کیپ ورد به جام جهانی ۲۰۲۶ یک رویداد تاریخی برای این کشور است
- بروسیا دورتموند خرید یک جواهر را فعال کرد
- نیوکاسل در حال برنامهریزی برای خریدهای جدید است
- زنگ خطر در دروازهبانی منچسترسیتی به صدا درآمده است
- منچستر یونایتد و چلسی میتوانند برای جذب این بازیکن ۱۷ ساله برزیلی با ارزش ۶۰ میلیون یورو رقابت کنند
- نیکولا، سرمربی کرمونزه: واردی عادات خودش را دارد، اما او برای ما یک الگو است
- جرمی بوگا و ترماس موفی پس از حمله هواداران، قصد ترک نیس را دارند
- فرانچسکو توتی، از بازی با آاس رم هیجانزده است
- بارسلونا - اتلتیکو مادرید | واکنشهای شخصیتهای اصلی بازی
- دو نام برای تقویت خط حمله آث میلان
- گواردیولا گفت که با دوناروما در مورد محرومیت احتمالی صحبت نخواهد کرد
- مودریچ درباره زیدان: او هاله خاصی داشت، فوتبال را از درون و بیرون میشناخت
- اسلات پیش از دیدار لیگ برتر مقابل ساندرلند، درباره مصدومان لیورپول صحبت کرد
- آنها در را برای کریستانتوس اوچه باز میکنند
- امضای قرارداد با هاروی بارنز اعلام شد
- آگسبورگ بدون مربی ماند
- «من هیچوقت جایی نرفتم.» این جمله را نارس، هافبک ناپولی، به شوخی در پاسخ به این سوال که آیا برگشته است یا نه، گفت
- کاپلو درباره کونته: به نظر میرسد آنتونیو در تیم به دنبال دشمن میگردد
- ترامپ: ما از نظر مالی در جنگ اوکراین دخالت نداریم
- این نوجوان ۱۵ ساله پرویی در کوهستان، فینال کوپا لیبرتادورس را تفسیر کرد
- گزینه جدید برای جیمز رودریگز
- لحظه سرنوشتساز برای آنتونیو رودیگر
- «مطمئنم لوانته را نجات میدادم»
- نیوکاسل یونایتد میخواهد تیم خود را با کامارا، هافبک موناکو، تقویت کند
- آرسنال میتواند ماینا، بازیکن منچستریونایتد را برای جایگزینی اودگارد به خدمت بگیرد
- مارسکا، سرمربی چلسی، فاش کرد که پالمر میتواند در بازی مقابل لیدز یونایتد به میدان برود
- زین الدین زیدان، لوکا مودریچ را تحت تاثیر قرار داد
- کانر گالاگر، فروش ۳۰ میلیون یورویی
- چرخش رادیکال با مارکوس رشفورد




































































































